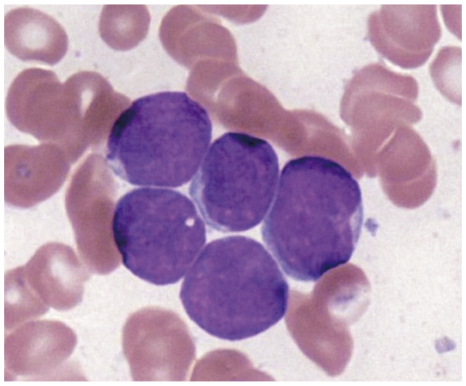

問題:
3歳の男児。発熱と下肢痛を主訴に両親に連れられて来院した。
1か月前に左足をひねって疼痛を自覚した。その後右下肢の疼痛も訴えるようになった。
2週間前に38℃台の発熱が出現し、両下肢の疼痛も増強した。
かかりつけ医を受診して抗菌薬を内服したが、発熱が持続している。
身長 103cm、体重 17kg。体温 37.5℃。脈拍 128/分、整。血圧 106/70 mmHg。
両側下腿に紫斑を数個認める。眼瞼結膜は貧血様である。
眼球結膜に異常を認めない。咽頭に発赤を認めない。心音と呼吸音に異常を認めない。
腹部は平坦、軟で、肝・脾を触知しない。表在リンパ節を触知しない。
下肢に関節腫脹や可動域制限を認めない。
血液所見:赤血球 298万、Hb 7.2g/dL、Ht 23%、網赤血球 1.8%、白血球 15,400(桿状核好中球 3%、分葉核好中球 8%、好酸球 1%、単球 4%、リンパ球 84%)、血小板 2.0万。
血液生化学所見:総蛋白 7.5g/dL、アルブミン 4.4g/dL、総ビリルビン 0.3mg/dL、直接ビリルビン 0.1mg/dL、AST 45U/L、ALT 19U/L、LD 520U/L(基準 190~365)、ALP 180U/L(基準 115~359)、CK 60U/L(基準 43~270)、尿素窒素 10mg/dL、クレアチニン 0.3mg/dL、尿酸 6.2mg/dL、Na 140mEq/L、K 4.0mEq/L、Cl 101mEq/L、Ca 11.0mg/dL、P 6.0mg/dL。CRP 1.2mg/dL。
両下肢エックス線写真で異常を認めない。
骨髄血塗抹May-Giemsa染色標本(別冊No.1)を別に示す。
可能性が高い疾患はどれか。
- a. 骨髄炎
- b. 骨肉腫
- c. 急性白血病
- d. 再生不良性貧血
- e. 血球貪食性リンパ組織球症
【クリックして答えを表示】
正解:c. 急性白血病(急性リンパ性白血病を疑う)
最低限これだけ覚えろ!【解説①】
・発熱+下肢痛+紫斑 → これはもう白血病サインの代表パターン。
→ なぜ?:白血病細胞が骨髄を圧迫(=骨痛)、正常な造血ができず出血傾向(=紫斑)
・白血球↑+リンパ球優位、Hb↓、Plt↓ → 汎血球減少+異常リンパ球増殖
→ 一見WBCは「増えている」が、その実体は白血病細胞(=がん化したリンパ球)。
→ 正常な白血球・赤血球・血小板は作られず減っている=「見かけ上WBC↑でも、実質は汎血球減少」と考える!
・LDH↑ → 細胞破壊が進んでいる
→ 典型的な急性リンパ性白血病(ALL)の初発パターン!
普通の解説【解説②】
小児の白血病(特にALL)は、関節痛や骨痛から始まることが多く、
整形外科や感染症として誤診されることもある。
この症例のように:
- ✔ 下肢の痛み → 骨髄内の白血病細胞の増殖による骨痛(骨髄の腫脹)
- ✔ 発熱が持続
- ✔ 眼瞼結膜の貧血様所見 → 赤血球減少による貧血
- ✔ 両下腿の紫斑 → 血小板減少による出血傾向
- ✔ WBC↑ だがリンパ球偏位(→ 白血病細胞)
- ✔ Hb・Pltともに低下 → 汎血球減少
- ✔ LDH↑ → 骨髄細胞の異常増殖・破壊
→ これだけ揃えば白血病を第一に疑うべき!
超わかりやすくて詳しい解説【解説③】
◆ 急性リンパ性白血病(ALL)の代表的症状
- ・原因がはっきりしない発熱が持続(抗菌薬を使っても改善しない)
- ・骨痛(特に下肢)
- ・出血傾向(紫斑・鼻出血など)
- ・貧血(顔色不良、元気がない)
- ・白血球数は高くても、ほとんどがリンパ球(=白血病細胞)
→ 骨髄抑制(正常血球が作れない)と腫瘍性増殖(白血病細胞だけが増える)が同時に起こる病態。
◆ 他の選択肢を見てみよう
- a. 骨髄炎:
多くは片側性、局所の熱感や腫脹あり。WBC↑だがリンパ球優位は違う。- 【疾患概要】 骨に細菌が感染して起こる化膿性炎症。発熱・局所の発赤・圧痛・腫脹が典型で、CRPや好中球が上昇する。 小児では長管骨に多く、血行性の単側性発症が多い。
- b. 骨肉腫:
腫瘍性疾患だが、貧血やPlt低下などの血球異常はなし。- 【疾患概要】 骨原発の悪性腫瘍。多くは10〜20代で、大腿骨・脛骨など成長板に近い部位に好発。 腫瘍局所の腫脹・疼痛・発赤が目立ち、血球異常は伴わない。
- d. 再生不良性貧血:
汎血球減少はあるが、WBC↑やLDH↑は出にくい。- 【疾患概要】 骨髄での造血そのものが低下する疾患。原因は特発性、薬剤、放射線など。
全血球が減少するが、白血球の構成比に異常はなく、LDHも通常は正常。
骨髄穿刺で脂肪化した骨髄(低形成)が特徴的。
- 【疾患概要】 骨髄での造血そのものが低下する疾患。原因は特発性、薬剤、放射線など。
- e. 血球貪食症候群:
発熱や血球減少はあるが、通常CRPは高値。LDHもより強く上がる。- 【疾患概要】 免疫の異常により、活性化したマクロファージが正常な血球を貪食(食べる)ことで血球減少が起こる。
高熱・肝脾腫・高フェリチン・LDH↑・トリグリセリド↑が特徴で、致死率が高く緊急対応が必要。
- 【疾患概要】 免疫の異常により、活性化したマクロファージが正常な血球を貪食(食べる)ことで血球減少が起こる。
◆ まとめ
小児+発熱+骨痛+紫斑+汎血球減少 → これだけ揃えば白血病を疑え!
この問題は画像を見ずとも、血液データと症状だけで十分正解にたどりつける構成です。











コメントを残す